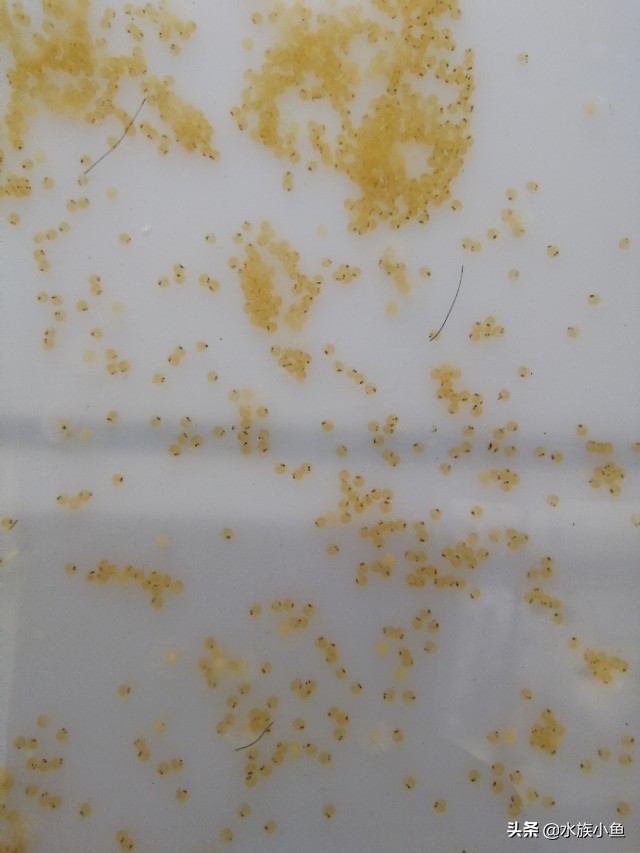
第一次繁殖宠物,自己繁殖锦鲤

锦鲤是一种高贵的大型观赏鱼,拥有缤纷的色彩、千变万化的花纹、沉稳的游姿!
多姿多彩的锦鲤

但在自然条件下,锦鲤排精、产卵不太同步,受精卵的孵化率及苗种成活率极低,这就需要人工繁殖。
锦鲤的繁殖适龄一般在3-10龄,体重达到1.5kg以上。选择亲鱼时,亲鱼应具有良好的体型、较强的抗病力,其次就是要有健壮的体质、色泽晶莹、品种特征明显、游姿稳健、无病无伤。
大的为雌鱼,两条小一些的是雄鱼

繁殖期要将亲鱼配组,一般雌、雄鱼以1:2~3的配比,1:1也可以。
雌雄鱼的识别
雌鱼从外观上看,雌鱼身体短粗而丰满,腹部膨大,胸鳍顶部呈圆形。雄鱼身体较瘦长,胸鳍顶部略尖,在胸鳍第一根鳍条和鳃盖上有若干白色“追星”。

2月底就要开始对锦鲤加强投喂,保证性腺发育的需要。催产一般在5月中旬,时间提前到4月中下旬也可以。最好是水温可以稳定在20℃左右的时候催产。
催产完之后可以让其自然产卵,在产卵池挂好鱼巢,并进行微流水刺激。注意产卵池和鱼巢的消毒,一定要到位。也可以进行人工授精,将雌鱼的卵和雄鱼的精液挤出,然后混合,在室内孵化。
之后就是等待鱼卵的孵化和育苗了。
晚上7点左右打完催产针

第二天人工挤卵、受精,等待孵化

受精后第二天,可以看到一双黑色眼睛
受精第三天,不分卵已经孵化出小锦鲤苗

孵化完小锦鲤苗,之后就是鱼苗的工作了,育苗才是锦鲤繁殖的关键点,想要了解锦鲤后续的育苗工作吗?
下期为大家介绍人工繁殖要点,欢迎关注我哦!